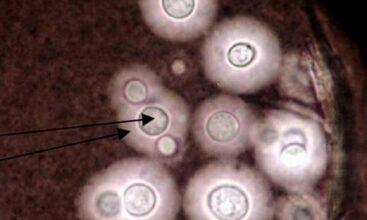
Santé publique: 20 ans et toujours pas de cadre réglementaire contre les mycotoxines

Tag: IMA

Présentation à Casablanca des résultats du 1er baromètre de la gouvernance responsable au Maroc
15 décembre 2023Les résultats du premier baromètre de la gouvernance responsable au Maroc, lancé par la Confédération générale des entreprises du Maroc (CGEM), l'Institut marocain des administrateurs (IMA), le Club des femmes administrateurs (CFA) et Ethics and Boards, ont été présentés le vendredi 15 décembre à Casablanca.

L’ambassadeur de France à Alger candidat à la présidence de l’IMA (médias)
22 février 2023Sur le départ, l'ambassadeur de France en Algérie, François Gouyette, a manifesté son intérêt pour la présidence de l'Institut du monde arabe, rapporte le quotidien français "La Lettre A".

Jack Lang reconduit à la tête de l’Institut du monde arabe
6 mars 2020Le président de l'Institut du monde arabe (IMA), Jack Lang a été reconduit pour trois ans à la tête de l'IMA.

L'IMA lance un certificat international de maîtrise de la langue arabe
15 avril 2019L'Institut du monde arabe (IMA) a annoncé le lancement d'un certificat international de maîtrise de la langue arabe (CIMA), la première certification en langue moderne reconnue au niveau mondial.

Centrafrique: Le président démissionne sous la pression internationale
10 janvier 2014Le président centrafricain Michel Djotodia, accusé par la communauté internationale de passivité face aux violences interreligieuses dans son pays, a démissionné vendredi à N'Djamena sous la pression des dirigeants d'Afrique centrale qui l'y avaient convoqué pour un sommet extraordinaire.
Santé publique: 20 ans et toujours pas de cadre réglementaire contre les mycotoxines
3 juin 2013Les pluies tardives du mois de mai ont faciliter la contamination des récoltes par les mycotoxines avec des risques de santé publique.
Quoi de neuf?
Rendez-vous partenaires
Newsletter
Abonnez-vous à nos newsletter et alerts.





















